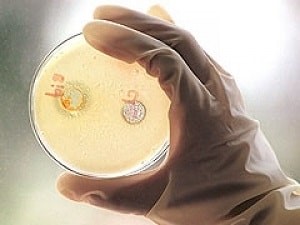
Как передается гепатит В Как передается гепатит В

Добрый день, дорогие домоседы. Как передается гепатит Б в быту? В данной статье будет описано то, как именно человек заражается такой болезнью, как вирусный гепатит Б, а также пути лечения и меры предосторожности.
К великому сожалению, в России гепатит Б становится все более популярным недугом. Встречается этот недуг в период с 20 до 49 лет. До изобретения вакцины этим заболеванием страдало еще большее количество народа, но время идет вперед, а вместе с этим развивается и медицина.
Что касается развивающихся африканских и азиатских стран, там в группу риска входит 10% населения. Раковые опухоли на печени и, собственно, гепатит в этой местности является буквально одной из самых распространенных причин смертности. Те, кто заразился, погибают в 25% случаев.
Говоря о тех местах, где можно заразиться данной болезнью, стоит упомянуть о салонах, где делают пирсинг и татуаж, также, о маникюрных салонах и, конечно же, в местах, где неоднократно принимаются наркотические средства.
Парадокс, но заразиться гепатитом можно и в лечебных учреждениях, а происходит это, чаще всего, через контакт с кровью зараженного человека.
С географической точки зрения наиболее подвержены гепатиту страны Юго-Восточной Азии, Африки и Южной Америки.
Симптомы гепатита Б на начальной стадии
Зарождение и развитие гепатита.
Развитие вирусного гепатита точно так же, как и любых других болезней, протекает с большим инкубационным периодом, который длится от 50 дней до 6 месяцев. В это время проявления практически незаметны, но все же имеются. Человека могут беспокоить такие симптомы, как:
- Гипертермия.
- Ломота в костях и мышцах.
- Тошнота или рвота.
- Головные боли и головокружение.
- Сухость кожи и пожелтение склер глаз.
- Кровоточивость и желтизна кожи .
- Носовые кровотечения.
- Кровоточащие десна.
- Диарея или запоры.
Гепатитом обычно болеют те, кто рождается в неблагополучных семьях. Чаще всего те люди, которые перенесли гепатит без надлежащего лечения, заболевают циррозом печени. Как гласит статистика этого года, уровень заболеваемости данным недугом составляет около 10%.
Врачи отмечают, что гепатит Б передается в быту через контакт с зараженной кровью и биологическими жидкостями. Основные пути передачи включают использование общих игл, нестерильных медицинских инструментов и предметов личной гигиены, таких как бритвы или зубные щетки. Важно помнить, что вирус может сохраняться на поверхностях, поэтому соблюдение мер предосторожности является ключевым. Специалисты рекомендуют использовать одноразовые инструменты и тщательно обрабатывать любые раны. Также следует избегать совместного использования личных вещей и регулярно проводить дезинфекцию поверхностей. Вакцинация остается самым эффективным способом защиты от гепатита Б, и врачи настоятельно советуют проходить вакцинацию всем, кто находится в группе риска.

Пути заражения гепатитом
Рассматривая вопрос о том, как именно распространяется гепатит Б, стоит привести список примеров, наиболее яркими из которых являются:
- Совместная эксплуатация одного предмета личной гигиены больным и здоровым человеком (бритье, использование общей зубной щетки и так далее).
- Прием наркотических веществ либо лечебные инъекции, производимые через 1 шприц.
- Во время родов естественным путем (при прохождении ребенка через половые пути).
- При процедуре пирсинга либо татуажа.
- При половом сношении с лицом, являющимся носителем недуга.
- При производимом переливании крови, если донор уже заразился недугом заранее.
- При проведении различных оперативных вмешательств лицам, являющимся носителями заболевания.
- Получение процедур иглоукалывания.
Как передается гепатит Б половым путем
Половой путь передачи инфекции.
Возможен и тот вариант, когда здоровый партнер может подхватить гепатит от полового партнера во время незащищенного сексуального контакта. Общая вероятность заболеть составляет в среднем около 30%.
Шансы поймать гепатит возрастают в несколько раз, если больной имеет несколько половых партнеров. Внешний вид обычно не играет роли при распознании больного гепатитом, так что всегда стоит быть начеку, чтобы нечаянно не стать жертвой данной инфекции.
Очень эффективным способом защиты является прививка, которая поможет выработать иммунитет к данному заболеванию. Очень важно при малейшей настороженности вставать на учет в специальное учреждение для венерических больных.
Как передается гепатит Б от матери ребенку? Гепатит может быть заразен в том случае, если ребенок родится от зараженной матери. Тогда малышу в первые месяцы жизни делается специальная прививка. Заболевание не передается через молоко, потому естественное вскармливание грудью не возбраняется.
Заражение может случиться еще в утробе матери и при родах, если плацента была каким-то образом повреждена.
Гепатит Б – это вирусное заболевание, которое вызывает воспаление печени и может передаваться различными путями. В быту основными способами передачи являются контакт с зараженной кровью и биологическими жидкостями. Люди часто обсуждают важность соблюдения мер предосторожности, таких как использование индивидуальных средств гигиены: зубных щеток, бритвенных принадлежностей и маникюрных инструментов. Также рекомендуется избегать совместного использования предметов, которые могут содержать кровь. Важно помнить, что вирус не передается через обычные бытовые контакты, такие как объятия или рукопожатия. Вакцинация – один из самых эффективных способов защиты от гепатита Б, и многие люди подчеркивают необходимость информирования о рисках и профилактических мерах, чтобы снизить вероятность заражения.

Бытовые пути заражения гепатитом Б
Возможно и то, что болезнь может передаться в процессе обычной жизни, в быту. Это касается следующих категорий граждан:
- Гомосексуалистов и лесбиянок.
- Лиц, имеющих неограниченное количество половых партнеров, ведущих непорядочный образ жизни.
- Наркозависимых, употребляющих тяжелые наркотические средства путем инъекций.
- Работников медицинской сферы.
- Больных с почечной недостаточностью, нуждающихся в периодических переливаниях или чистках крови.
- Не привитых членов семьи больного гепатитом.
Не нужно опасаться контактировать с подобными больными, так как болезнь может передаться только при тесном взаимодействии. Прививка от гепатита может на всю жизнь обезопасить от заражения.
Диагностика гепатита Б
Чтобы диагностировать гепатит Б, необходимо сдать специальный анализ крови на наличие гена HBsAg, а также специфических антител. Если содержание данного гена высокое, то это может свидетельствовать о заражении. Также, стоит сдать кровь на печеночные пробы и лейкоциты, так как эти показатели в случае заражения резко снижаются.
Те, кто является носителем гена, потенциально опасны для окружающих, а контактирующим лицам срочно требуется обязательная вакцинация. При осмотре и опросе пациента врач должен провести краткий опрос, в ходе которого должно быть выяснено:
- Принимает или принимал ли пациент наркотики
- Производилось ли переливание крови в ходе реанимационных мероприятий либо операций
- Имеются ли на теле повреждения или раны открытого типа.
- Очень хорошо помогает определить наличие гепатита ультразвуковая диагностика эластометрия.
- Биохимический анализ крови на содержание антигенов и антител является очень важной ступенью диагностики.

Как не заболеть гепатитом Б
Для того, чтобы не заболеть гепатитом, нужно своевременно получить введение вакцины. Если прививка уже была сделана, то иммунитет автоматически начинает защиту и прививаться дополнительно не следует.
Переболевшие гепатитом ранее тоже не входят в группу риска, так как к тому времени в организме уже образуется защитный барьер.
Снижение иммунных сил организма тоже может дать большой толчок к развитию заболевания, потому нужно тщательно работать над защитой здоровья. При половом сношении лучше использовать контрацептивы либо пить противозачаточные препараты.
Желтуха новорожденных. Для защиты от гепатита новорожденных детей используется иммуноглобулин, который вводится в первые моменты жизни младенца.
При соблюдении элементарных правил личной гигиены риск заражения гепатитом родственников больного значительно снижается.
При условии, если один из супругов не имеет гепатита, то риск заражения весьма высок и второму супругу обязательно необходима прививка.
Полное обследование тоже имеет огромное значение в постановке диагноза и подборе необходимого лечения. Чем раньше будет проведено обследование, тем быстрее можно будет начать принимать соответственные меры.
Как бороться с ожирением печени? Читайте по ссылке. Как передается гепатит Б в быту мы рассказали. В заключение хочется сказать о том, что гепатит Б не настолько страшен, как думают многие. Стоит только начать действовать.
Вопрос-ответ
Сколько живет вирус гепатита Б на предметах?
Вирус гепатита В может выживать до 7 дней вне тела человека при комнатной температуре на предметах, поверхностях окружающей среды.
Что сделать, чтобы гепатит не заразить близких?
Использование презерватива практически исключает вероятность заражения вирусным гепатитом при половом контакте. Важно также привить всех членов семьи от гепатита В, что полностью исключит заражение этим заболеванием.
Что делать, если контактировал с больным гепатитом Б?
Если возможное заражение произошло вирусом гепатита В, то надо сразу делать прививку от гепатита В, причем по срочной схеме. Если возможное заражение произошло вирусом гепатита С, то возможно назначение курса противовирусной терапии на короткий срок. Это может сделать только врач гепатолог. Срочно обратитесь к нему.
Можно ли заразиться гепатитом Б через полотенце?
Вирус В гораздо заразнее, чем С: достаточно, чтобы в небольшую трещину на коже или слизистой попало микроколичество выделений инфицированного человека. Именно поэтому для гепатита В актуален даже контактно-бытовой способ передачи (например, через общее полотенце).
Советы
СОВЕТ №1
Избегайте использования общих предметов личной гигиены, таких как бритвы, зубные щетки и маникюрные принадлежности. Эти предметы могут стать источником передачи вируса гепатита Б, так как могут содержать капли крови или другие биологические жидкости.
СОВЕТ №2
При оказании первой помощи или уходе за людьми с гепатитом Б всегда используйте перчатки. Это поможет предотвратить контакт с кровью и другими биологическими жидкостями, которые могут содержать вирус.
СОВЕТ №3
Регулярно проводите дезинфекцию поверхностей в вашем доме, особенно в местах, где могут быть следы крови, например, в ванной комнате или на кухне. Используйте дезинфицирующие средства, которые эффективны против вирусов.
СОВЕТ №4
Обсудите с вашим врачом возможность вакцинации против гепатита Б, особенно если вы находитесь в группе риска. Вакцинация является одним из самых эффективных способов защиты от этого вируса.